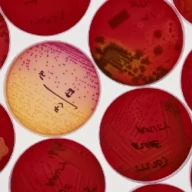
کشت باکتری در ژل آگار قرمز در ظروف پتری

لیوفیلیزاسیون باکتری: راهنمای جامع خشک کردن انجمادی کشت باکتریایی
آموزش کامل لیوفیلیزاسیون یا خشک کردن انجمادی کشت باکتری. این راهنما شامل مراحل، تجهیزات مورد نیاز و نکات کلیدی برای نگهداری طولا...
آموزش کامل لیوفیلیزاسیون یا خشک کردن انجمادی کشت باکتری. این راهنما شامل مراحل، تجهیزات مورد نیاز و نکات کلیدی برای نگهداری طولا...

با این راهنمای جامع، نحوه ساخت بافر TAE (تریس-استات-EDTA) را به آسانی و در چند گام یاد بگیرید. دستورالعمل تهیه محلول استوک و محل...

سفیدپوستی در جامعه آمریکا فراتر از رنگ پوست است. با مفهوم سفیدپوستی، امتیازات ناعادلانه، کلیشههای فرهنگی و نحوه شکلگیری هویت س...

قزاقستان، کشوری پهناور با تاریخ غنی و فرهنگی متنوع! از جمعیت و زبانها تا اقتصاد، جغرافیا و حکومت، با حقایق جالب و تاریخچه قزاقس...

تحلیل جامع شخصیت هملت، شاهزاده افسرده دانمارک در تراژدی شکسپیر. بررسی عمیق اندوه، انتقام، تردید و تحول هملت. کشف پیچیدگیهای روا...

کروم، فلزی براق با کاربردهای فراوان از فولاد ضد زنگ تا رنگدانههای درخشان! با 10 حقیقت جالب درباره این عنصر، از خواص مغناطیسی تا...

سوئد، گوهری در اسکاندیناوی! با جغرافیای متنوع، از دشتهای جنوبی تا کوههای غربی و آب و هوای معتدل تا قطبی، مقصدی جذاب برای کاوشگ...

اوبلک چیست و چرا رفتاری عجیب دارد؟ کشف خواص شگفتانگیز این سیال غیرنیوتنی، از قدم زدن روی آن تا بررسی اثرات تغلیظ برشی. با ما هم...

آیا مورچه آتشین در خانه شما لانه کرده؟ آموزش گام به گام شناسایی مورچه آتشین، لانههای مورچه آتشین و رفتارهای تهاجمی آنها. از خط...

کشف حقایق جالب درباره زینون، گاز نجیب کمیاب! از کاربرد زینون در چراغهای خودرو و موتورهای یونی تا ترکیبات شیمیایی و نقش آن در رآ...